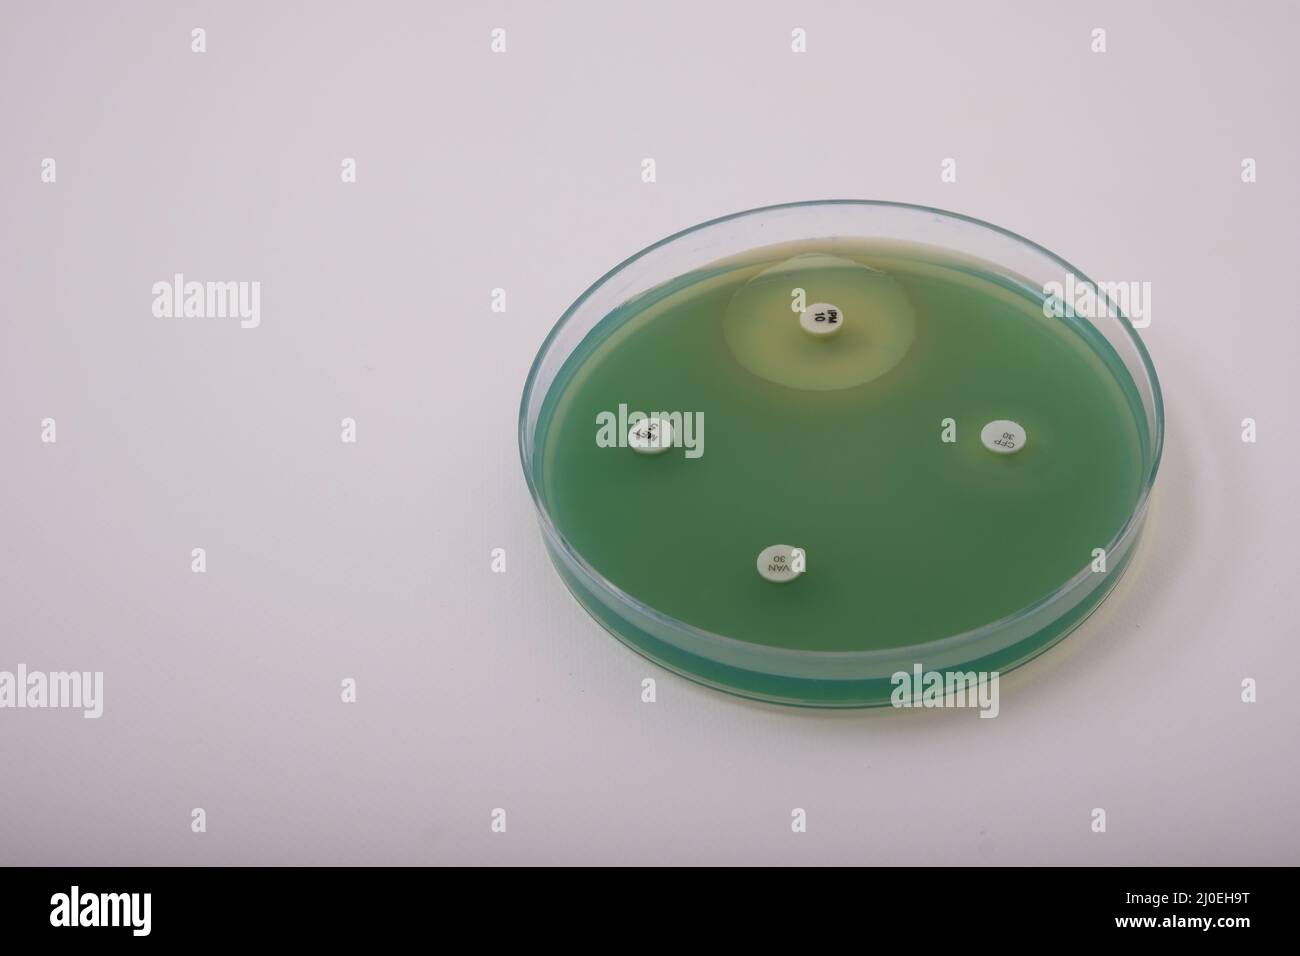
foto della crescita di batteri pseudomonas su agar nutriente con dischi antibiotici per testare la resistenza Foto Stock
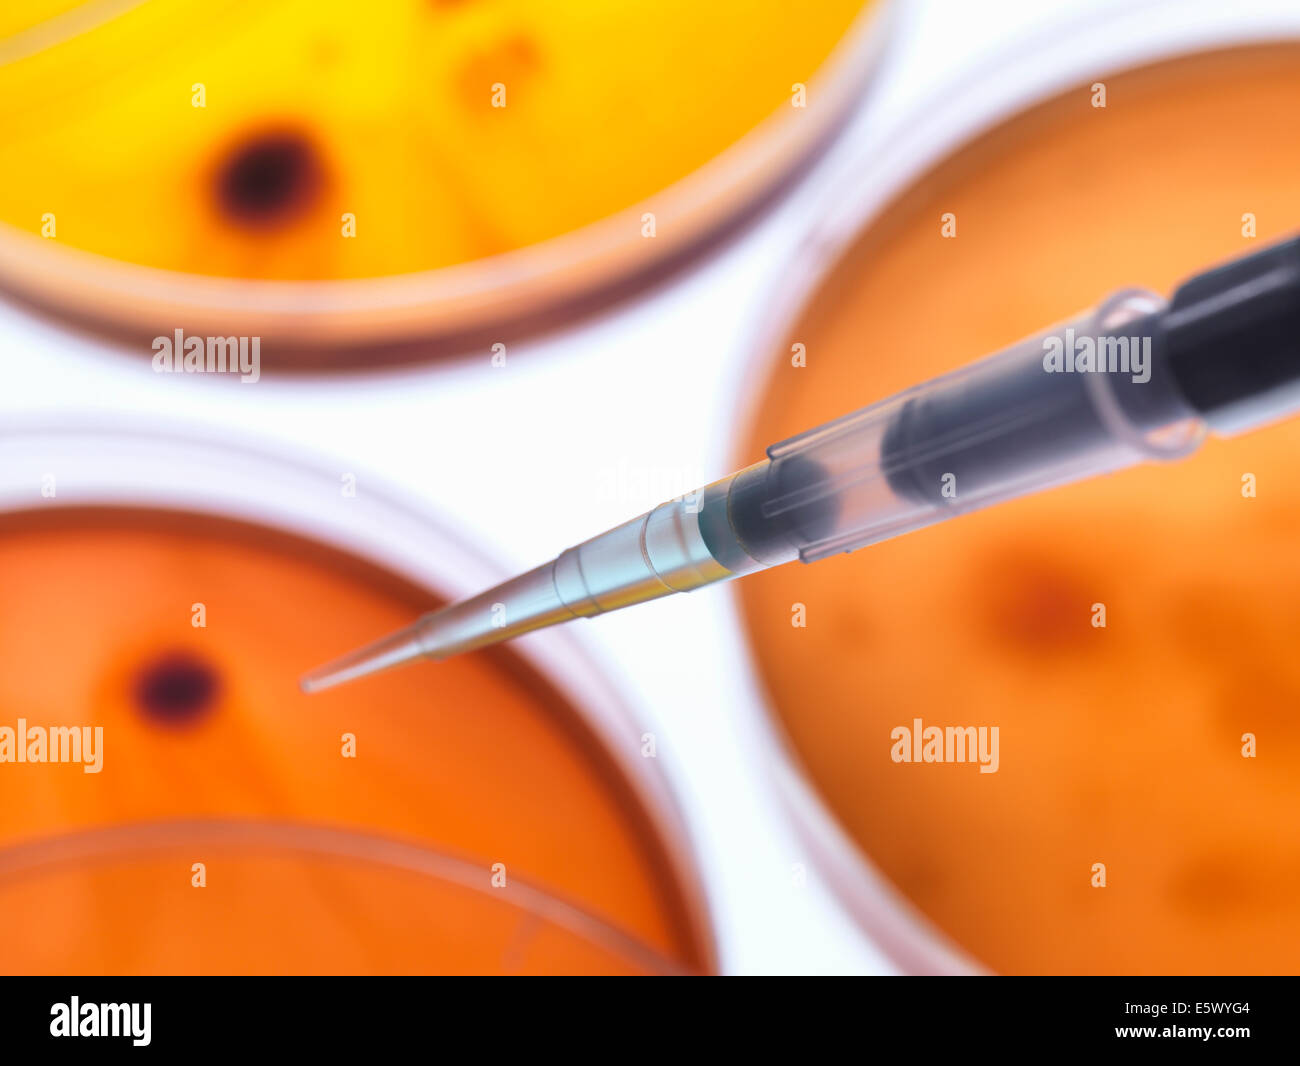
Scienziato il pipettaggio di campione in una capsula petri contenente batteri coltivati in un laboratorio di microbiologia Foto Stock
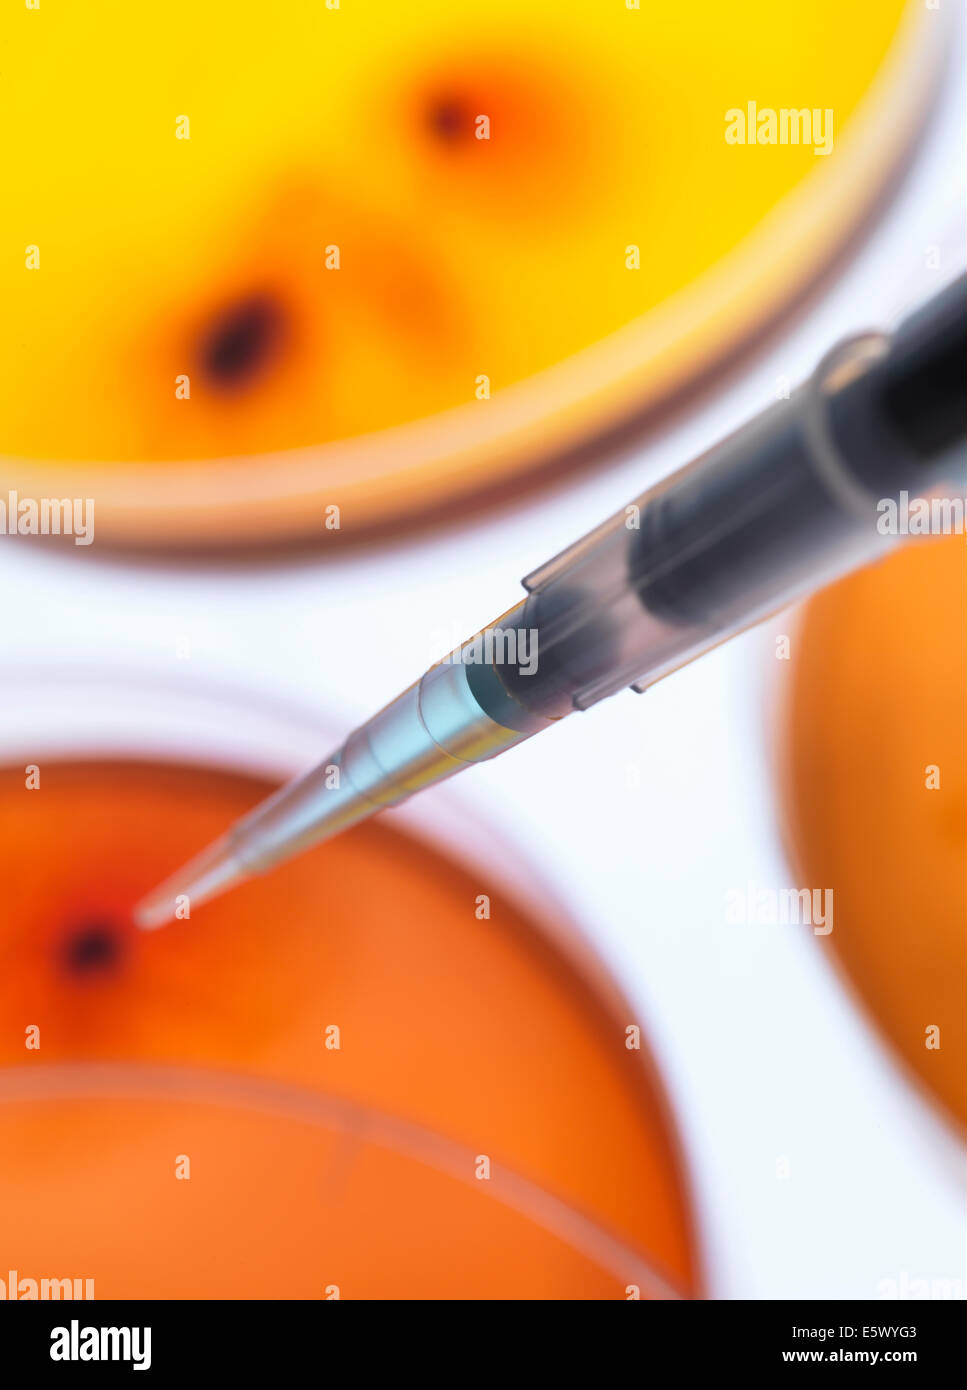
Scienziato il pipettaggio di campione in una capsula petri contenente batteri coltivati in un laboratorio di microbiologia Foto Stock
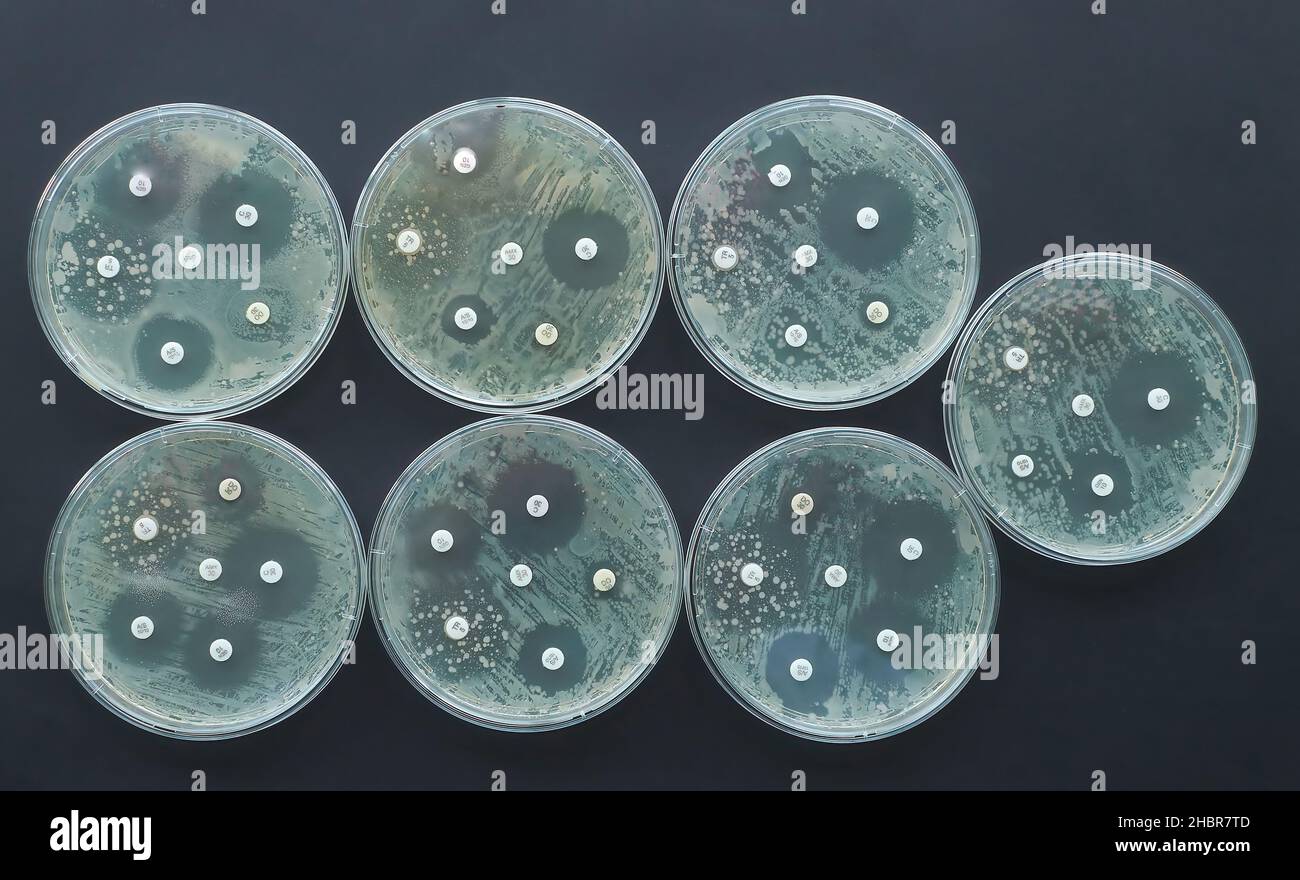
Test di suscettibilità antimicrobica antibiogramma resistenza agli antibiotici batteri Foto Stock
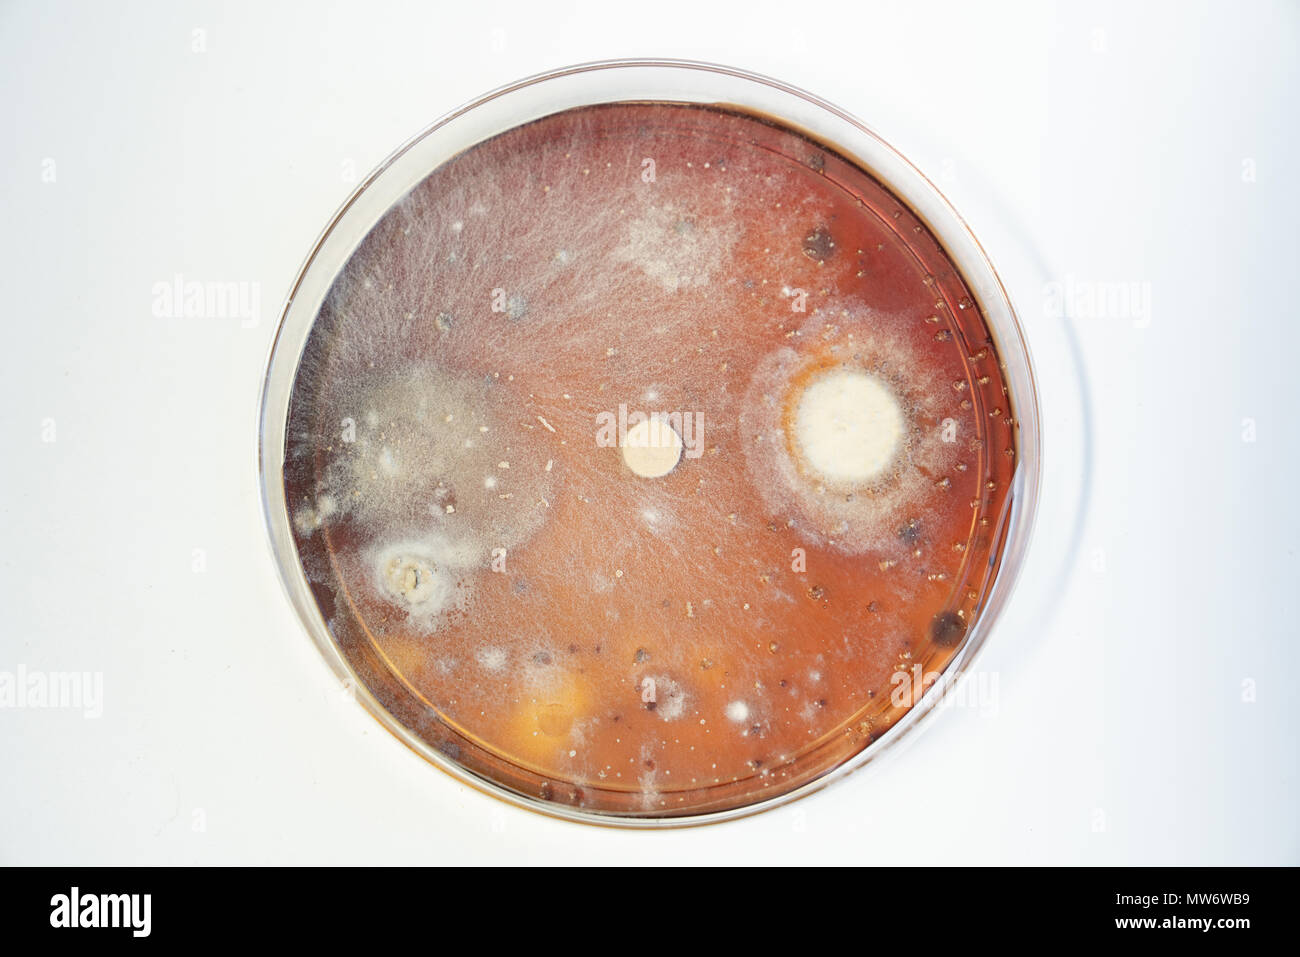
Piastra di petri con colonie di batteri Foto Stock

Test dei batteri Immagini Stock
(33,753)Filtri rapidi:
Test dei batteri Immagini Stock

RMFRHJ2M–Streptotest, test di diagnostica per determinare la causa di angina : virus o batteri (streptoccoque).

RF2RGM9JR–Test di colorazione Gram. Piastra di Petri in vetro con coltura di batteri Gram-negativi Escherichia coli dopo l'uso di colorazione viola-cristallina. Primo piano del Gram-positivo

RF2B8M25F–Mani nei guanti per uso medico. Arrestare il virus. Basta il panico. Coronavirus. Quarantena

RF2BC330G–Provetta per analisi del sangue con Coronavirus la malattia di COVID 19 per analisi e ricerca dei virus. Concentrarsi sul test del sangue.

RF2E12MT1–Il chimico dell'impianto di trattamento delle acque reflue (WWTP) spiega il test di settlibilità a un gruppo di ispettori governativi che aggiornano le proprie certificazioni.

RM2F77BME–Qui si utilizzano batteri radioattivi per studiare la capacità di diversi saponi e detergenti di pulire il lavaggio. Feeded con materiale radioattivo, i batteri sono stati poi posti su piccoli pezzi di tessuto, ciascuno poi lavato con saponi diversi. Se un singolo batterio radioattivo rimane sul pezzo di tessuto, questo può essere trovato. Il tecnico nella foto esamina con Geiger counter la quantità di batteri radioattivi rimasti su tali pezzi di tessuto.

RMB1RFA4–Eosina-fuxin test, test di sputo e i batteri responsabili della tubercolosi, quella di Howrah, Hooghly, West Bengal, India

RFT6YA02–Attrezzature da laboratorio per la centrifugazione del sangue. Concetto di immagine di un esame del sangue. 3D'illustrazione.

RF2K37JEW–medico prendendo tampone nasofaringeo di riccio ragazzo per l'esame in laboratorio medico per rilevare batteri naso o coronavirus. Test PCR

RMFRHJ2N–Streptotest, test di diagnostica per determinare la causa di angina : virus o batteri (streptoccoque).

RF2RRG36R–Test di colorazione Gram. Una capsula di Petri in vetro con coltura batterica patogena prima e dopo l'uso Crystal Violet. Batteri macchiati con viola genziana. Gram-po

RMD4N10C–Nel febbraio 2009, la FDA ha condotto un test a Irvine, California, su campioni di pesce per potenziali agenti patogeni, tra cui la Salmonella. Il laboratorio ha utilizzato metodi di arricchimento batterico per identificare la contaminazione. I risultati sono stati parte degli sforzi in corso per garantire la sicurezza dei prodotti ittici e prevenire i rischi per la salute pubblica derivanti da prodotti contaminati.

RF2M6MBMF–righello di misurazione interpretazione del test con disco di resistenza agli antibiotici antimicrobici

RF2K5B4HX–HAZMAT SUIT scienziato, analisi al microscopio e di laboratorio, test del dna e sviluppo di vaccini per il rischio di batteri medici. Team di esperti scientifici

RMEEK5HC–Un laboratorio di patologia tecnico utilizzando un bastoncino di cotone su una capsula di Petri con una coltura di batteri
RF2JB5N6W–Formazione dello stelo concetto isometrico icone composizione con immagini di microscopio e batteri con illustrazione vettoriale delle provette

RFT6CH0C–Attrezzature da laboratorio per la centrifugazione del sangue. Concetto di immagine di un esame del sangue. 3D'illustrazione.

RF2E12MM4–L'operatore dell'impianto di trattamento delle acque reflue spiega una tecnica per misurare la profondità dei fanghi attivi nella parte inferiore di un chiarificatore delle acque reflue.

RF2HPR1R3–I batteri Gram negativi non trattengono la macchia di cristallo viola. I batteri Gram positivi danno un risultato positivo nel test di colorazione Gram. Confronto
RF2J0EH9T–foto della crescita di batteri pseudomonas su agar nutriente con dischi antibiotici per testare la resistenza

RF2HFKRJA–Bastoncino di cotone su fondo bianco in microfibra. Controllo della contaminazione e test per la ricerca di batteri. Pulire lo sfondo bianco neve dopo il controllo.

RF2APJTM0–Analisi cellulare, duplicazione cellulare, studio di malattie infettive. Visione microscopica di microrganismi e batteri. Esame del sangue dei globuli rossi

RMB63MM8–Esame del sangue in bottiglie di coltura in incubatore che viene testato per la crescita batterica.

RFF52N0A–Il virus di Ebola nello Zaire il sangue del pannello di prova campione di laboratorio tenuto da tecnico di laboratorio. Etichetta è fittizia.

RF2AT6JAG–Provette di sangue nella centrifuga. Immagine concettuale degli esami del sangue, delle malattie e della ricerca genetica e di laboratorio.

RME8KPGH–Batteri di Salmonella, una causa comune di avvelenamento di cibo, di invadere una cellula immune.

RF2DH781C–Test della suscettibilità dei batteri agli antibiotici. Batteri che crescono in una piastra di Petri riempita con agar. Esperimento. Il metodo dell'agar a diffusione su disco viene verificato

RF2BE9FF3–Illustrazione vettoriale di una piastra Petri con microbi. Batteri di ricerca di laboratorio

RFR50B67–Alcuni vasi di laboratorio tubo con sangue samplest, etichettati con codici a barre e simboli di avvertenza e i campioni sono infettati o avere qualche potenziale pericolo
RFE5WYG4–Scienziato il pipettaggio di campione in una capsula petri contenente batteri coltivati in un laboratorio di microbiologia

RFF52T8C–Provetta per la raccolta di sangue con il virus di Ebola etichetta di prova sul diagramma di medici.

RFFFB7X7–Attrezzature da laboratorio per la centrifugazione del sangue. Concetto di immagine di un esame del sangue.

RME8KPGE–Batteri di Salmonella, una causa comune di avvelenamento di cibo, di invadere una cellula immune.

RME5REDG–Test diagnostici per determinare la carica virale o batterica (streptococcus) causa di angina.

RF3D6AKM8–Agglutinazione batterica. Test medico per il rilevamento di agenti patogeni. Le cellule batteriche si aggrappano. Interazione dell'antigene anticorpale IgM. Epitopi. Immunoaggregazione.

RF2M46EXJ–Un test rapido per gli streptococchi del gruppo A con esito positivo si trova su una maschera chirurgica. Questi batteri causano malattie tonsillite e scarlatto febbre.
RFE5WYG3–Scienziato il pipettaggio di campione in una capsula petri contenente batteri coltivati in un laboratorio di microbiologia

RFF52N1B–Il virus di Ebola nello Zaire il sangue del pannello di prova campione di laboratorio tenuto da tecnico di laboratorio.

RFER8X92–Robot a mano che tiene una piastra petri con colonie di batteri e funghi. Immagine 3D con profondità di campo.

RME8KPYW–Micrografia elettronica a scansione di S. aureus batteri sfuggire la distruzione da umani cellule bianche del sangue.

RF2AW2RTE–fase di crescita dei batteri vettoriali. batterio in capsule di petri isolato su fondo bianco.